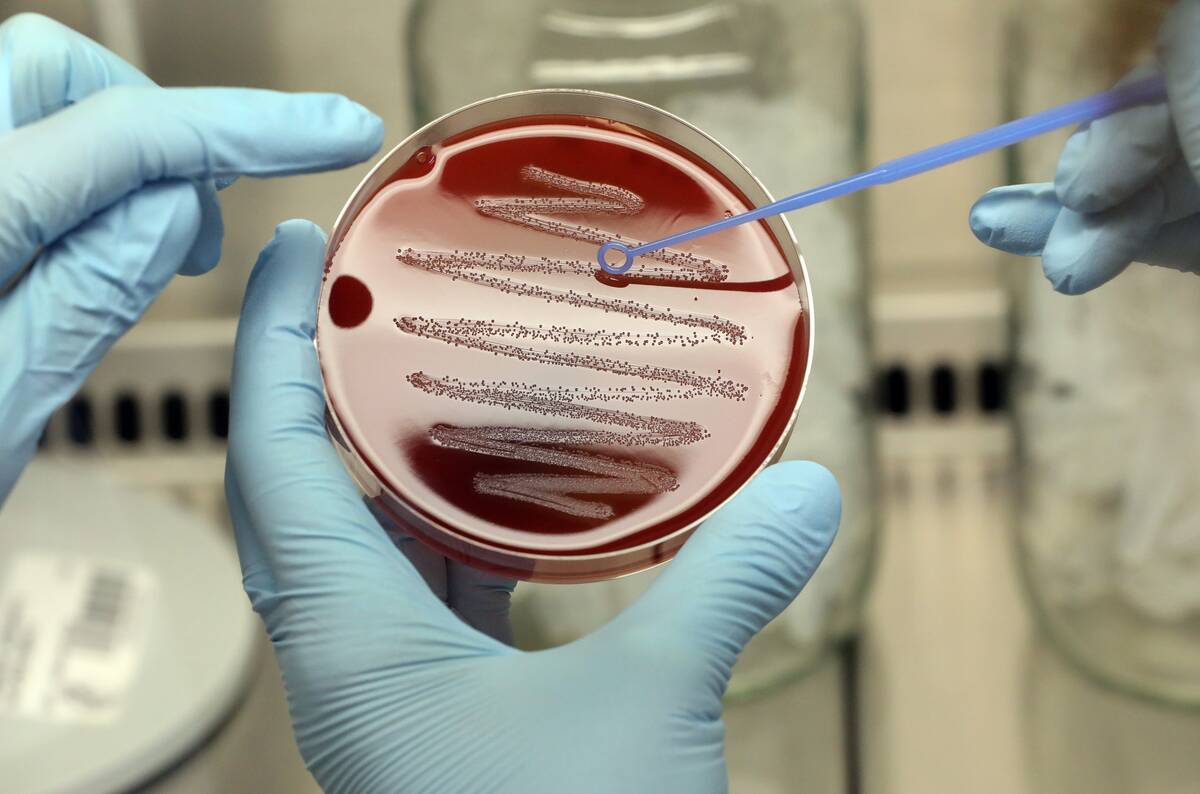
dpa-story: Microbiology at Max-Planck-Institute

The science and obstacles behind reviving extinct species
Imagine walking alongside a woolly mammoth or hearing the call of the passenger pigeon once more. The idea of bringing extinct species back to life may sound like science fiction, but it’s a burgeoning field of scientific research.
Extinct species revival, or de-extinction, captures the imagination and raises intriguing possibilities. It challenges our understanding of biology, ethics, and the very fabric of life itself, promising a future where the past and present collide.
A Brief History of Extinction: How Did We Get Here?

Extinction has been a natural part of Earth’s history, with events like the asteroid impact that wiped out the dinosaurs. However, human activities have accelerated the loss of species in recent times. Habitat destruction, pollution, and overhunting have driven countless species to extinction.
The dodo and the Tasmanian tiger are infamous examples of species lost due to human influence. Understanding this history is crucial as we consider reversing the trend through de-extinction.
The Role of Genetic Engineering in Modern Science

Genetic engineering has revolutionized our ability to manipulate DNA, opening doors once thought impossible. Techniques like CRISPR allow precise editing of genetic material, crucial for de-extinction projects. This technology not only aids in potentially reviving lost species but also in conserving endangered ones.
Its applications are vast, from agriculture to medicine, highlighting its transformational impact on modern science. Yet, it also raises ethical and ecological questions about its use.
Jurassic Park: Science Fiction or Foreshadowing?

The blockbuster movie Jurassic Park introduced many to the concept of bringing extinct creatures back to life. While the film’s dinosaurs remain fiction, it sparked real-world interest in de-extinction.
Scientists today ponder if we could, and should, revive species like the woolly mammoth using preserved DNA. The movie serves as both inspiration and cautionary tale, reminding us of the potential risks and ethical dilemmas inherent in such ambitious scientific endeavors.
The First Successful De-Extinction: The Pyrenean Ibex

In 2003, scientists achieved the first de-extinction with the Pyrenean ibex, albeit briefly. Cloning brought a specimen back to life for seven minutes before it succumbed to lung defects. This milestone demonstrated the feasibility of de-extinction, though it highlighted significant challenges.
The ibex’s short-lived revival emphasized the complexities involved in cloning, including genetic defects and the need for suitable surrogate species. It marked a pivotal point in de-extinction research.
How Scientists Choose Which Species to Revive

Choosing which species to resurrect involves a mix of scientific, ecological, and ethical considerations. Scientists often prioritize species with available DNA and ecological roles that could benefit current ecosystems. The woolly mammoth, for example, could help restore tundra environments.
Public interest and funding availability also play roles in these decisions. Ultimately, the choice requires balancing potential ecological benefits against the risks of reintroducing a species into today’s world.
The Woolly Mammoth: A Mammoth Undertaking in Genetic Engineering

The woolly mammoth is a prime candidate for de-extinction, with efforts led by teams like that of Harvard’s George Church. The goal is to create a mammoth-elephant hybrid using CRISPR to insert mammoth genes into elephant DNA.
This project aims to combat climate change by reviving the mammoth’s role in maintaining permafrost. While promising, it faces challenges, including ethical concerns and ensuring the hybrid can survive in modern ecosystems.
Passenger Pigeons: From Billions to None, and Back Again?

Once numbering in the billions, passenger pigeons were driven to extinction in the early 20th century. De-extinction projects aim to bring them back using DNA from museum specimens. The goal is to reintroduce them to forests they once populated, which could help restore ecological balance.
However, this endeavor faces hurdles, including recreating the pigeon’s social behaviors and ensuring a suitable habitat. It’s a compelling challenge for conservationists and geneticists alike.
The Science Behind Resurrection: CRISPR and Cloning Techniques

CRISPR technology and cloning are at the heart of de-extinction efforts. CRISPR allows precise editing of genomes, essential for inserting extinct species’ DNA into living relatives. Cloning, as demonstrated with the Pyrenean ibex, involves transferring the nucleus from a preserved cell of an extinct species into an egg cell of a closely related species, which then develops in a surrogate.
These techniques, while groundbreaking, are complex and require overcoming significant biological challenges. They represent the cutting edge of biotechnology, offering hope for de-extinction yet demanding careful application.
Potential Environmental Impacts of Bringing Back Extinct Species

Reintroducing extinct species could have varied environmental impacts. On the positive side, it might restore lost ecological functions, like the mammoth’s role in maintaining permafrost. However, there’s a risk of disrupting current ecosystems, potentially leading to unforeseen consequences.
Revived species might compete with existing wildlife or fail to adapt to modern environments. Careful consideration of ecological dynamics is crucial to minimizing negative impacts and ensuring successful integration of these species into today’s ecosystems.
The Ethics of Reviving Extinct Species: Is It Right or Wrong?
The ethics of de-extinction spark heated debate. Proponents argue it offers a chance to correct past wrongs and restore ecosystems. Critics caution against unforeseen ecological impacts and the moral implications of “playing God.” There’s concern about diverting resources from conserving extant species.
Ultimately, the ethical debate hinges on balancing potential benefits with risks, and whether humanity has the right to intervene in such profound ways. It’s a discussion that continues to evolve as technology advances.
The Role of Biotechnology Companies in De-Extinction Efforts

Biotechnology companies are pivotal in advancing de-extinction projects, providing funding, resources, and expertise. Companies like Colossal Biosciences are at the forefront, collaborating with researchers to develop the necessary genetic engineering techniques.
Their involvement accelerates progress but also raises questions about commercialization and intellectual property. The partnership between science and industry is essential for pushing the boundaries of what’s possible, yet it requires careful navigation to align commercial interests with ethical and ecological considerations.
Current Challenges Facing Genetic Resurrection Projects

Genetic resurrection projects face numerous challenges, from technical hurdles to ethical dilemmas. Successfully extracting viable DNA from extinct species is difficult, often limited by degradation over time. Additionally, creating suitable habitats and ensuring the survival of revived species pose significant ecological challenges.
There’s also the question of long-term sustainability and the potential impact on biodiversity. Addressing these challenges requires interdisciplinary collaboration and a cautious approach to ensure responsible progress in de-extinction.
The Controversial Quest to Revive the Thylacine, or Tasmanian Tiger

The thylacine, or Tasmanian tiger, is a symbol of de-extinction’s allure and controversy. Extinct since the 1930s, efforts to revive the thylacine involve extracting DNA from preserved specimens. Scientists hope to reintroduce it to Tasmania, restoring ecological balance.
However, challenges abound, from incomplete DNA to ethical concerns over reintroducing predators. The quest to revive the thylacine encapsulates the broader de-extinction debate, as it explores the intersection of science, ethics, and conservation.